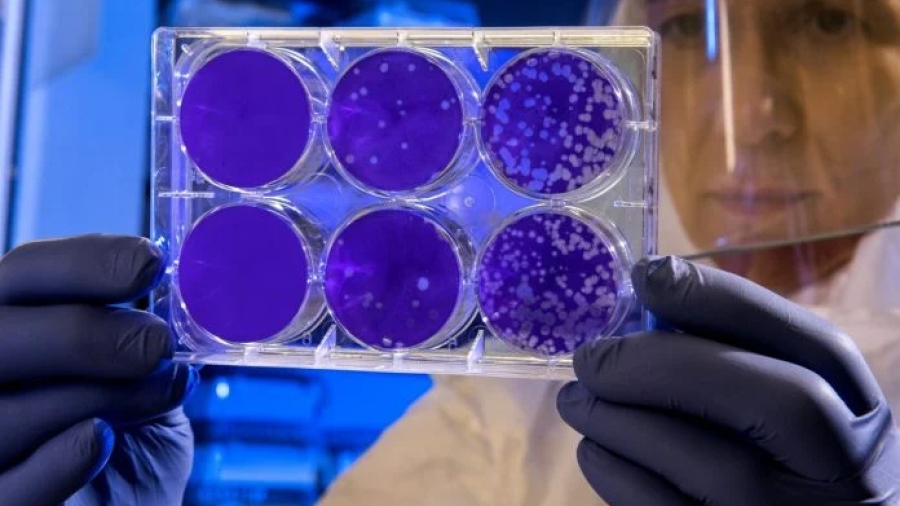
Αποκάλυψη: Για ποιους ιούς χρηματοδοτούσαν έρευνες στην Ουκρανία οι ΗΠΑ

Η ρωσική Κοινοβουλευτική Επιτροπή για τη διερεύνηση των δραστηριοτήτων αμερικανικών βιοεργαστηρίων στην Ουκρανία διαθέτει τεκμηριωμένα στοιχεία για την δραστηριότητα αυτών των βιοεργαστηρίων με τους ιούς hanta.
Αυτό αποκάλυψε η συμπρόεδρος της επιτροπής και αντιπρόεδρος της Κρατικής Δούμας Irina Yarovaya την Πέμπτη 5 Μαΐου μετά τα αποτελέσματα της πρώτης συνεδρίασης του επιστημονικού συμβουλευτικού συμβουλίου.
«Τα εργαστήρια ενδιαφέρονται για τους hantaviruses και γινόταν ενεργή εργασία προς αυτή την κατεύθυνση. Οι μελέτες που πραγματοποιήθηκαν με τη συμμετοχή στρατιωτικού προσωπικού αφορούσαν ειδικά τους hantaviruses. Για ποιο σκοπό, ποια κλιμάκωση και ποιές συνέπειες είναι ερωτήματα που θα απαντηθούν αργότερα, αλλά αυτή είναι η επίσημη πληροφορία από το Υπουργείο Άμυνας της Ρωσικής Ομοσπονδίας», είπε η Yarovaya.
Επισήμανε ότι στη σημερινή συνεδρίαση του διοικητικού συμβουλίου συμμετείχαν κορυφαίοι Ρώσοι επιστήμονες στον τομέα της βιολογίας, της ιολογίας και της χημείας. Όπως επισήμανε είναι «θεμελιωδώς σημαντικό» ότι οι προσκεκλημένοι εμπειρογνώμονες «ανεξαιρέτως επιβεβαίωσαν ότι γίνεται στρατιωτική-βιολογική έρευνα στην Ουκρανία:
«Δυστυχώς, έχουμε να κάνουμε με κλιμάκωση που πραγματοποιούν οι ΗΠΑ στο έδαφος άλλων κρατών όσον αφορά την οικοδόμηση ενός υπερεθνικού συστήματος διαχείρισης όχι μόνο για την επιδημιολογική κατάσταση, αλλά για την εκμετάλλευση, στην προκειμένη περίπτωση, του εδάφους της Ουκρανίας ως ανεξάρτητο πεδίο δοκιμών, το οποίο είναι επίσης επωφελές για τις φαρμακευτικές εταιρείες των ΗΠΑ που υλοποιούν έργα του Πενταγώνου».
Τόνισε τέλος ότι η Ρωσία εφαρμόζει τις διεθνείς συμφωνίες στον τομέα της ασφάλειας, ιδίως τη Σύμβαση του 1972 για την Απαγόρευση της Ανάπτυξης Βιολογικών Όπλων.
Ταυτόχρονα, επέστησε την προσοχή στο γεγονός ότι οι ΗΠΑ είναι εκείνες που εδώ και πολλά χρόνια αντιτίθενται στην υιοθέτηση συμφωνιών για την εφαρμογή αυτής της σύμβασης, που θα επέτρεπε τον πραγματικό έλεγχο των βιοτεχνολογιών.
Οι Ουκρανοί σβήνουν τα ίχνη
Ο εκπρόσωπος του ρωσικού υπουργείου Άμυνας, υποστράτηγος Igor Konashenkov, δήλωσε ότι έγινε «έκτακτη εκκαθάριση», από το καθεστώς του Κιέβου, για να εξαφανιστούν τα στρατιωτικού βιολογικού προγράμματος που εφαρμόζεται στην Ουκρανία και που χρηματοδοτείται από το Υπουργείο Άμυνας των ΗΠΑ. Σύμφωνα με τον ίδιο, ελήφθησαν πληροφορίες από υπαλλήλους ουκρανικών βιολογικών εργαστηρίων για την επείγουσα καταστροφή ιδιαίτερα επικίνδυνων παθογόνων στις 24 Φεβρουαρίου: πανώλη, άνθρακας, χολέρα και άλλες θανατηφόρες ασθένειες!!!
Η αναπληρώτρια υπουργός Εξωτερικών των ΗΠΑ Victoria Nuland στις 9 Μαρτίου, μιλώντας σε ακρόαση στην Επιτροπή Εξωτερικών Υποθέσεων της Γερουσίας των ΗΠΑ, παραδέχτηκε ότι υπάρχουν εγκαταστάσεις στην Ουκρανία όπου διεξάγεται έρευνα στον τομέα της βιολογίας.
Σύμφωνα με αυτήν, το Στέιτ Ντιπάρτμεντ «ανησυχεί ότι ο ρωσικός στρατός μπορεί να προσπαθεί να τις ελέγξει» και συνεργάζεται με την ουκρανική πλευρά για να διασφαλίσει ότι το Κίεβο μπορεί «να αποτρέψει αυτά τα ερευνητικά υλικά να πέσουν στα χέρια Ρώσων. δυνάμεις».
Το ρωσικό υπουργείο Άμυνας απάντησε λέγοντας ότι με αυτά τα λόγια η Νούλαντ επιβεβαίωσε τη συμμετοχή του Πενταγώνου σε στρατιωτικά βιολογικά προγράμματα στην Ουκρανία.
www.bankingnews.gr














Σχόλια αναγνωστών